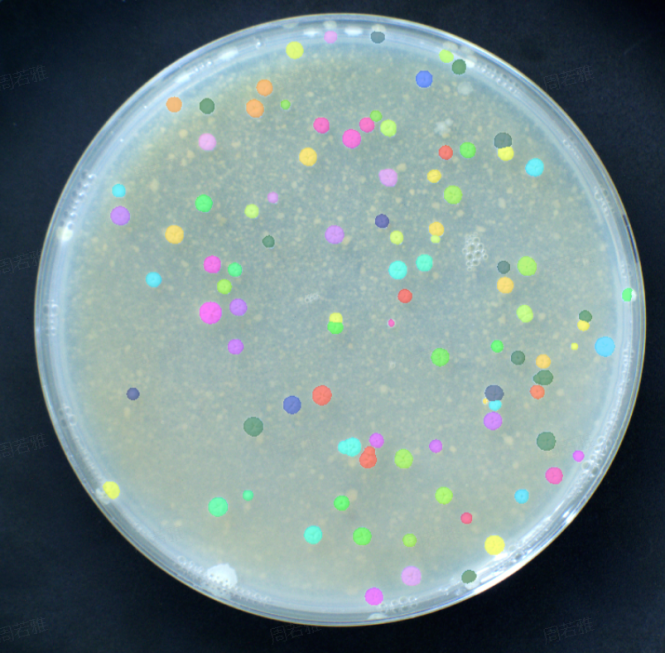

慧眼识“菌”,汇像智能微生物菌落挑选工作站用于链霉菌的双筛实验
在已知放线菌中,链霉菌是最大的族群,可产生高达一千多种的抗生物质,具备巨大的经济价值和医学意义,被人们称为天然药物的合成工厂。据报道,自然界中约有65%–70%的抗生素是由链霉菌及其近源放线菌产生的,由其所产生的多类次级代谢产物,如抗生素、免疫调节剂,在工农牧医等多领域已显现出广阔的应用前景。含有大量NPs途径的链霉菌成为后基因组时代最有希望的药物发现来源之一,特别是随着基因测序技术的飞速发展,人们发现链霉菌基因组中包含着极为丰富的天然产物生物合成基因簇资源。到目前为止,许多种类的NP已经在异源链霉菌宿主内合成表达成功,这意味着开发链霉菌底盘细胞作为异源表达宿主有其得天独厚的优势。

在实验阶段, 合成生物技术主要关注的是: (1) 工程DNA的构建; (2) 工程DNA在目标底盘系统中的功能测试. 其中,工程DNA在目标底盘系统中的构建流程包括细胞转化(热击、电转)、菌落涂布、菌落挑取、细胞裂解、荧光分选等。链霉菌菌落挑选作为关键步骤之一,存在链霉菌菌落致密干燥且坚硬多皱、培养基内固体颗粒的干扰严重、数量多,且链霉菌菌落挑选接种重复性高、工作量大、耗时长、溯源性差等问题。而汇像科技最新研发的“海黛兰(HedylaX)”智能微生物菌落挑选工作站,融合AI视觉识别技术,液体处理技术和自动化控制技术为一体,通过自动成像、智能识别和自动操作控制,抗背景干扰且全过程自动化挑选和涂布接种链霉菌菌落,高通量,助力解决挑菌实验过程遇到的痛点。
HedylaX “海黛兰”
智能微生物菌落挑选工作站
汇像科技 XImaging

海黛兰(HedylaX)工作站顶部的高效过滤系统能产生垂直向下气流确保设备内部百级洁净条件。它配备了一套使用一次性无菌挑菌涂布头的独立八通道移液/挑菌机械臂、一个实现各类耗材的开关盖与转移的移板机械手、超声探测和安全锁、触摸显示屏、2500w像素的工业级相机成像模块、紫外灯和状态指示灯等。
目前已完成的链霉菌相关挑菌涂布接种流程的研发测试
平皿——含抗性培养基的标准单孔板和含无抗性培养基的标准单孔板
平皿——含抗性培养基的标准24孔板和含无抗性培养基的标准24孔板
备注:其他的标准孔板也可以根据需求进行拓展开发,例如平皿——48孔板等。
链霉菌的双筛实验之菌落挑选
实验信息
· 原容器:平皿
· 目标容器:单孔板(含无抗性琼脂培养基)和单孔板(含抗性琼脂培养基)
· 菌种:链霉菌
· 挑菌模式:人工
· 挑菌方式:点选
· 接种板量:双板
· 接种方式:回型涂布

菌落识别参数
· 模型类型:链霉菌04
· 平均直径:2mm
· 直径范围:0.5-20mm
· 临近度:0mm
· 到边缘距离:10mm
流程


结论
1.菌落识别效果
识别单菌落103CFU,人工删除79CFU,自动化挑取24CFU链霉菌。

2.效率
从取一次性无菌挑菌涂布头、挑菌、2块单孔板涂布到丢弃涂布头,24个菌落全部挑菌接种完毕,耗时228s。
3.准确性 100%

含无抗性培养基的标准单孔板

含抗性培养基的标准单孔板
链霉菌的双筛实验展示了海黛兰(HedylaX)智能微生物菌落挑选工作站的高通量与自动化优势。微生物菌落挑选需要抗背景干扰、准确的菌落识别定位、琼脂高度的精准探测与交叉污染的风险规避,才能确保链霉菌挑菌具有100%的准确率。而海黛兰的机械结构设计、高清成像系统、AI识别算法、超声探测以及一次性无菌挑菌涂布头都完美保障了结果的精稳性。实验表明,“海黛兰(HedylaX)”智能微生物菌落挑选工作站不仅能完全避免培养基颗粒的干扰,还能在挑菌涂布的过程中不挂破琼脂,实现了1mm以上的链霉菌菌落自动化挑菌准确率达到100%。
相较人工挑菌,3000个链霉菌人工挑菌涂布需要大约4天完成,而海黛兰仅在1天内即可以完成所有的工作,海黛兰(HedylaX)完全可代替人工实现自动化操作,由此实现实验室24h无人化运转,缩短研发周期,赋能科研硕果累累,是微生物菌落挑选实验的理想解决方案。

一次性无菌挑菌球形涂布头
链霉菌是许多病原微生物的生防因子,也是目前研究应用广泛的生防菌。在可以预见的基因组时代,功能基因组研究将使人类深入了解链霉菌家族的基因组信息和次级代谢途径。通过运用组合生物合成手段,有针对性的改造基因、修饰酶结构、优化抗生素合成途径对链霉菌进行更合理高效的遗传操作,将为提高具有重要价值的天然代谢物产量和获得新代谢物创造更为有利的条件。
▷ 菌落挑选工作站怎样预防交叉污染?
a. 顶部装配有高效过滤系统,产生自上而下的垂直气流,是设备内部实现局部百级的洁净效果。
b. 配置紫外灯,工作前后开启对设备内部的表面进行消毒。
c. 一次性无菌挑菌头,挑菌耗材为一次性自动化耗材,一个菌落对应一个耗材,避免重复使用或消杀不彻底导致交叉污染
d. 固定的挑菌工位和接种工位,从而固定挑菌通道的运动路线,并就近丢弃挑菌头,避免其他的耗材容器等被污染。
▷ 琼脂的高度探测方向?
内部配置超声探测模块,探测程序通过多次的应用测试,可实现稍微不平整的琼脂高度表面的菌落挑选或涂布。
▷ 是否可以实现2块及以上的目标板接种?
可以。不仅可实现不同培养基的双筛接种,也可以实现相同培养基的菌落复制和重拍。
▷ 是否可以实现菌液涂布?
可以。可以将转化后的感受态细胞悬液接种到标准8孔板的固体培养基表面,通过涂布棒进行“回”字型或“Z"字型涂布接种。
BREAK AWAY
往期推荐
汇像科技 XImaging

---------------------------------------











